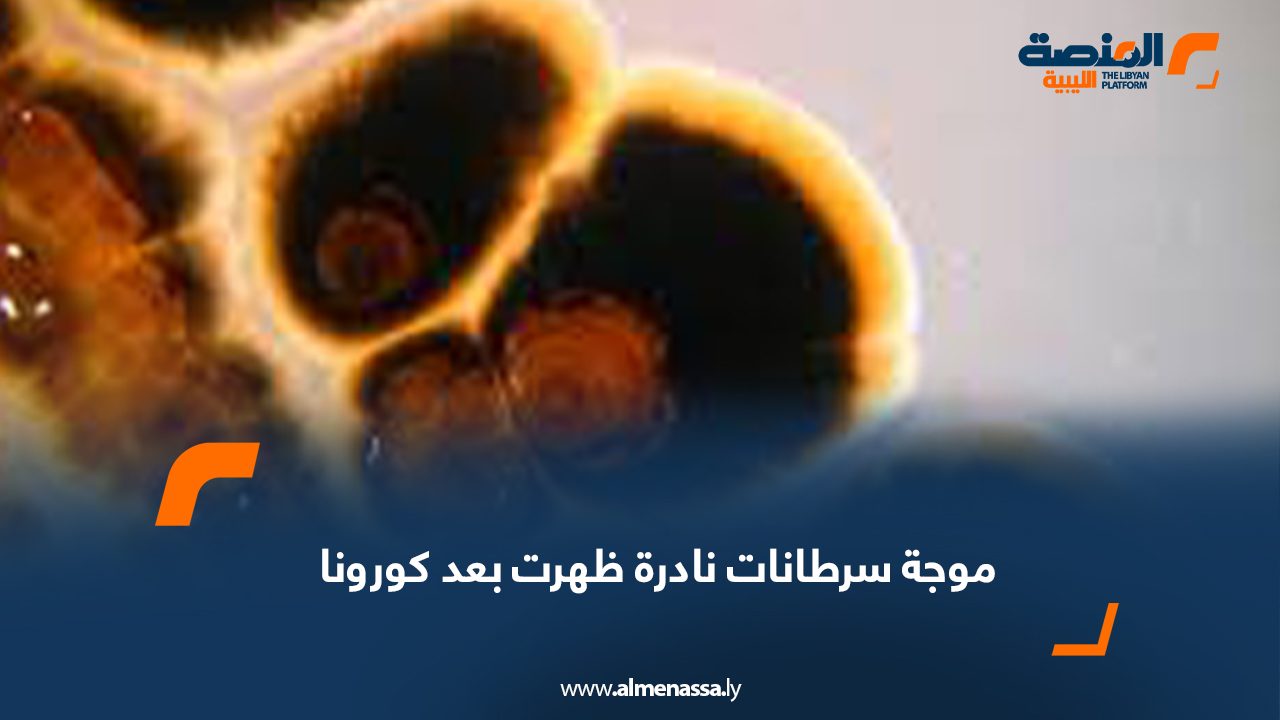

بعد وباء فيروس كورونا، بدأ الأطباء يشخصون سرطانات غير عادية ونادرة لدى أشخاص من مختلف الأعمار، ما أعاد فكرة معروفة لدى خبراء الصحة أن الفيروسات يمكن أن تسبب ظهور السرطان أو تعيده بسرعة إلى الواجهة.
وفكرة أن بعض الفيروسات يمكن أن تسبب السرطان أو تسرعه ليست جديدة. لقد أدرك العلماء هذا الاحتمال منذ ستينيات القرن العشرين ، واليوم، يقدر الباحثون أن 15 إلى 20 في المئة من جميع أنواع السرطان في جميع أنحاء العالم تنشأ من عوامل معدية مثل فيروس الورم الحليمي البشري والتهاب الكبد B.
من المحتمل أن تمر سنوات عديدة قبل أن يحصل العالم على إجابات قاطعة حول ما إذا كان فيروس كورونا وراء زيادة حالات السرطان .
وقال جون تي شيلر، الباحث في المعاهد الوطنية للصحة والرائد في دراسة الفيروسات المسببة للسرطان، إن مسببات الأمراض المعروفة بأنها تسبب السرطان تستمر في الجسم على المدى الطويل. لكن فئة فيروسات الجهاز التنفسي التي تشمل الإنفلونزا وكورونا تصيب المريض ثم تختفي عادة بدلا من البقاء ولا يعتقد أنها تسبب السرطان.
وقال ديفيد توفيسون، مدير مركز السرطان في مختبر كولد سبرينج هاربور والرئيس السابق للجمعية الأميركية لأبحاث السرطان، إنه لا يوجد دليل على أن فيروس كورونا يحول الخلايا مباشرة لجعلها سرطانية. لكن قد لا تكون هذه هي القصة الكاملة.
وأوضح توفيسون أن عددا من الدراسات الصغيرة والمبكرة، التي نشر الكثير منها خلال الأشهر التسعة الماضية، تشير إلى أن عدوى فيروس كورونا يمكن أن تحفز سلسلة التهابية واستجابات أخرى يمكن أن تؤدي، من الناحية النظرية، إلى تفاقم نمو الخلايا السرطانية.